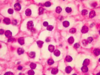

Horner ipsilateral , hipoestesia de la hemicara ipsilateral, inestabilidad y nistagmo por la afectación de los núcleos vestibulares, hipoestesia hemicuerpo contralateral, ataxia de miembros ipsilaterales, disartria y disfagia sin afectar la lengua ni la sensibilidad artrocinética y vibratoria ni hay hemiparesia
Síndrome de Wallenberg o bulbar lateral
Qué tumor disemina tipicamente a través del líquido cefalorraquídeo (LCR)
Meduloblastoma
Tto epilepsia mioclónica juvenil ( Síndrome de Janz)
Ácido valproico
( SI MUJER EN EDAD FÉRTIL: Lamotrigina o levetiracetam )
Tto pseudotumor cerebri
PL repetidas
Acetazolamida
Derivación lp LCR
Mujer de más de 40 años que presenta un dolor muy intenso al realizar ejercicio o esfuerzo y cursa con bajo nivel de consciencia
Hemorragia subaracnoidea ( ACA )
Mujer que presenta pérdida de termoalgesia en las EESS pero no en las EEII. Se ha hecho quemaduras sin darse cuenta

Siringomielia
Paciente joven que presenta a diario episodios de hormigueo periumbilical junto con movimientos bucales y posturas distónicas. No recuerda nada

Esclerosis hipocampo
Qué par craneal está afectado

IV
Hacia donde se desplazan lesiones en XII o V ( lengua y mandibula )
Hacia el lado de la lesión
Hacia donde se desplazan lesiones en IX ( paladar )
Lado sano
Tto dolor facial UL, breve y muy intenso en maxilar y mandibular en mujeres de 50 años tras masticar
Neuralgia del trigémino ( carbamazepina )
Sistema parasimpático

En qué áreas se divide la area motora 2a
A. Premotora ( unidad motora Proximal )
A. motora suplementaria ( unidad motora distal )
Sd Anton
Lesión en lobulo occipital que presenta ceguera cortical + anosognosia
Sd gestmann
Alexia, agrafia, agnosia digital, acalculia, desorientación D-I
DD AFASIAS

Paciente con verborrea que no comprende ordenes ni repite
Afasia Wernicke ( si repitiera transcortical sensitiva )
EMBOLIA ACM INFERIOR
Paciente con bloqueo en el habla que comprende ordenes pero no repite
Afasia Broca ( si repite transcortical motora )
EMBOLIA ACM SUPERIOR
Cuerpos geniculados Tálamo
Lateral : LUZ ( via óptica )
Medial : Musica ( via auditiva )
Por que agujero sale cada PC

PC en tronco del encefalo

PC afectados en el sd Tolosa-Hunt
( III, IV, V1-2, VI )
Oftalmopléjia UL y dolor retroorbitário por un proceso granulomatoso que afecta a la hendidura esfenoidal
PC afectados en el sd Foix
Hendidura esfenoidal ( III, IV, V1, VI )
PC afectados en el sd Vernet
Agujero rasgado ( IX,X,XI )